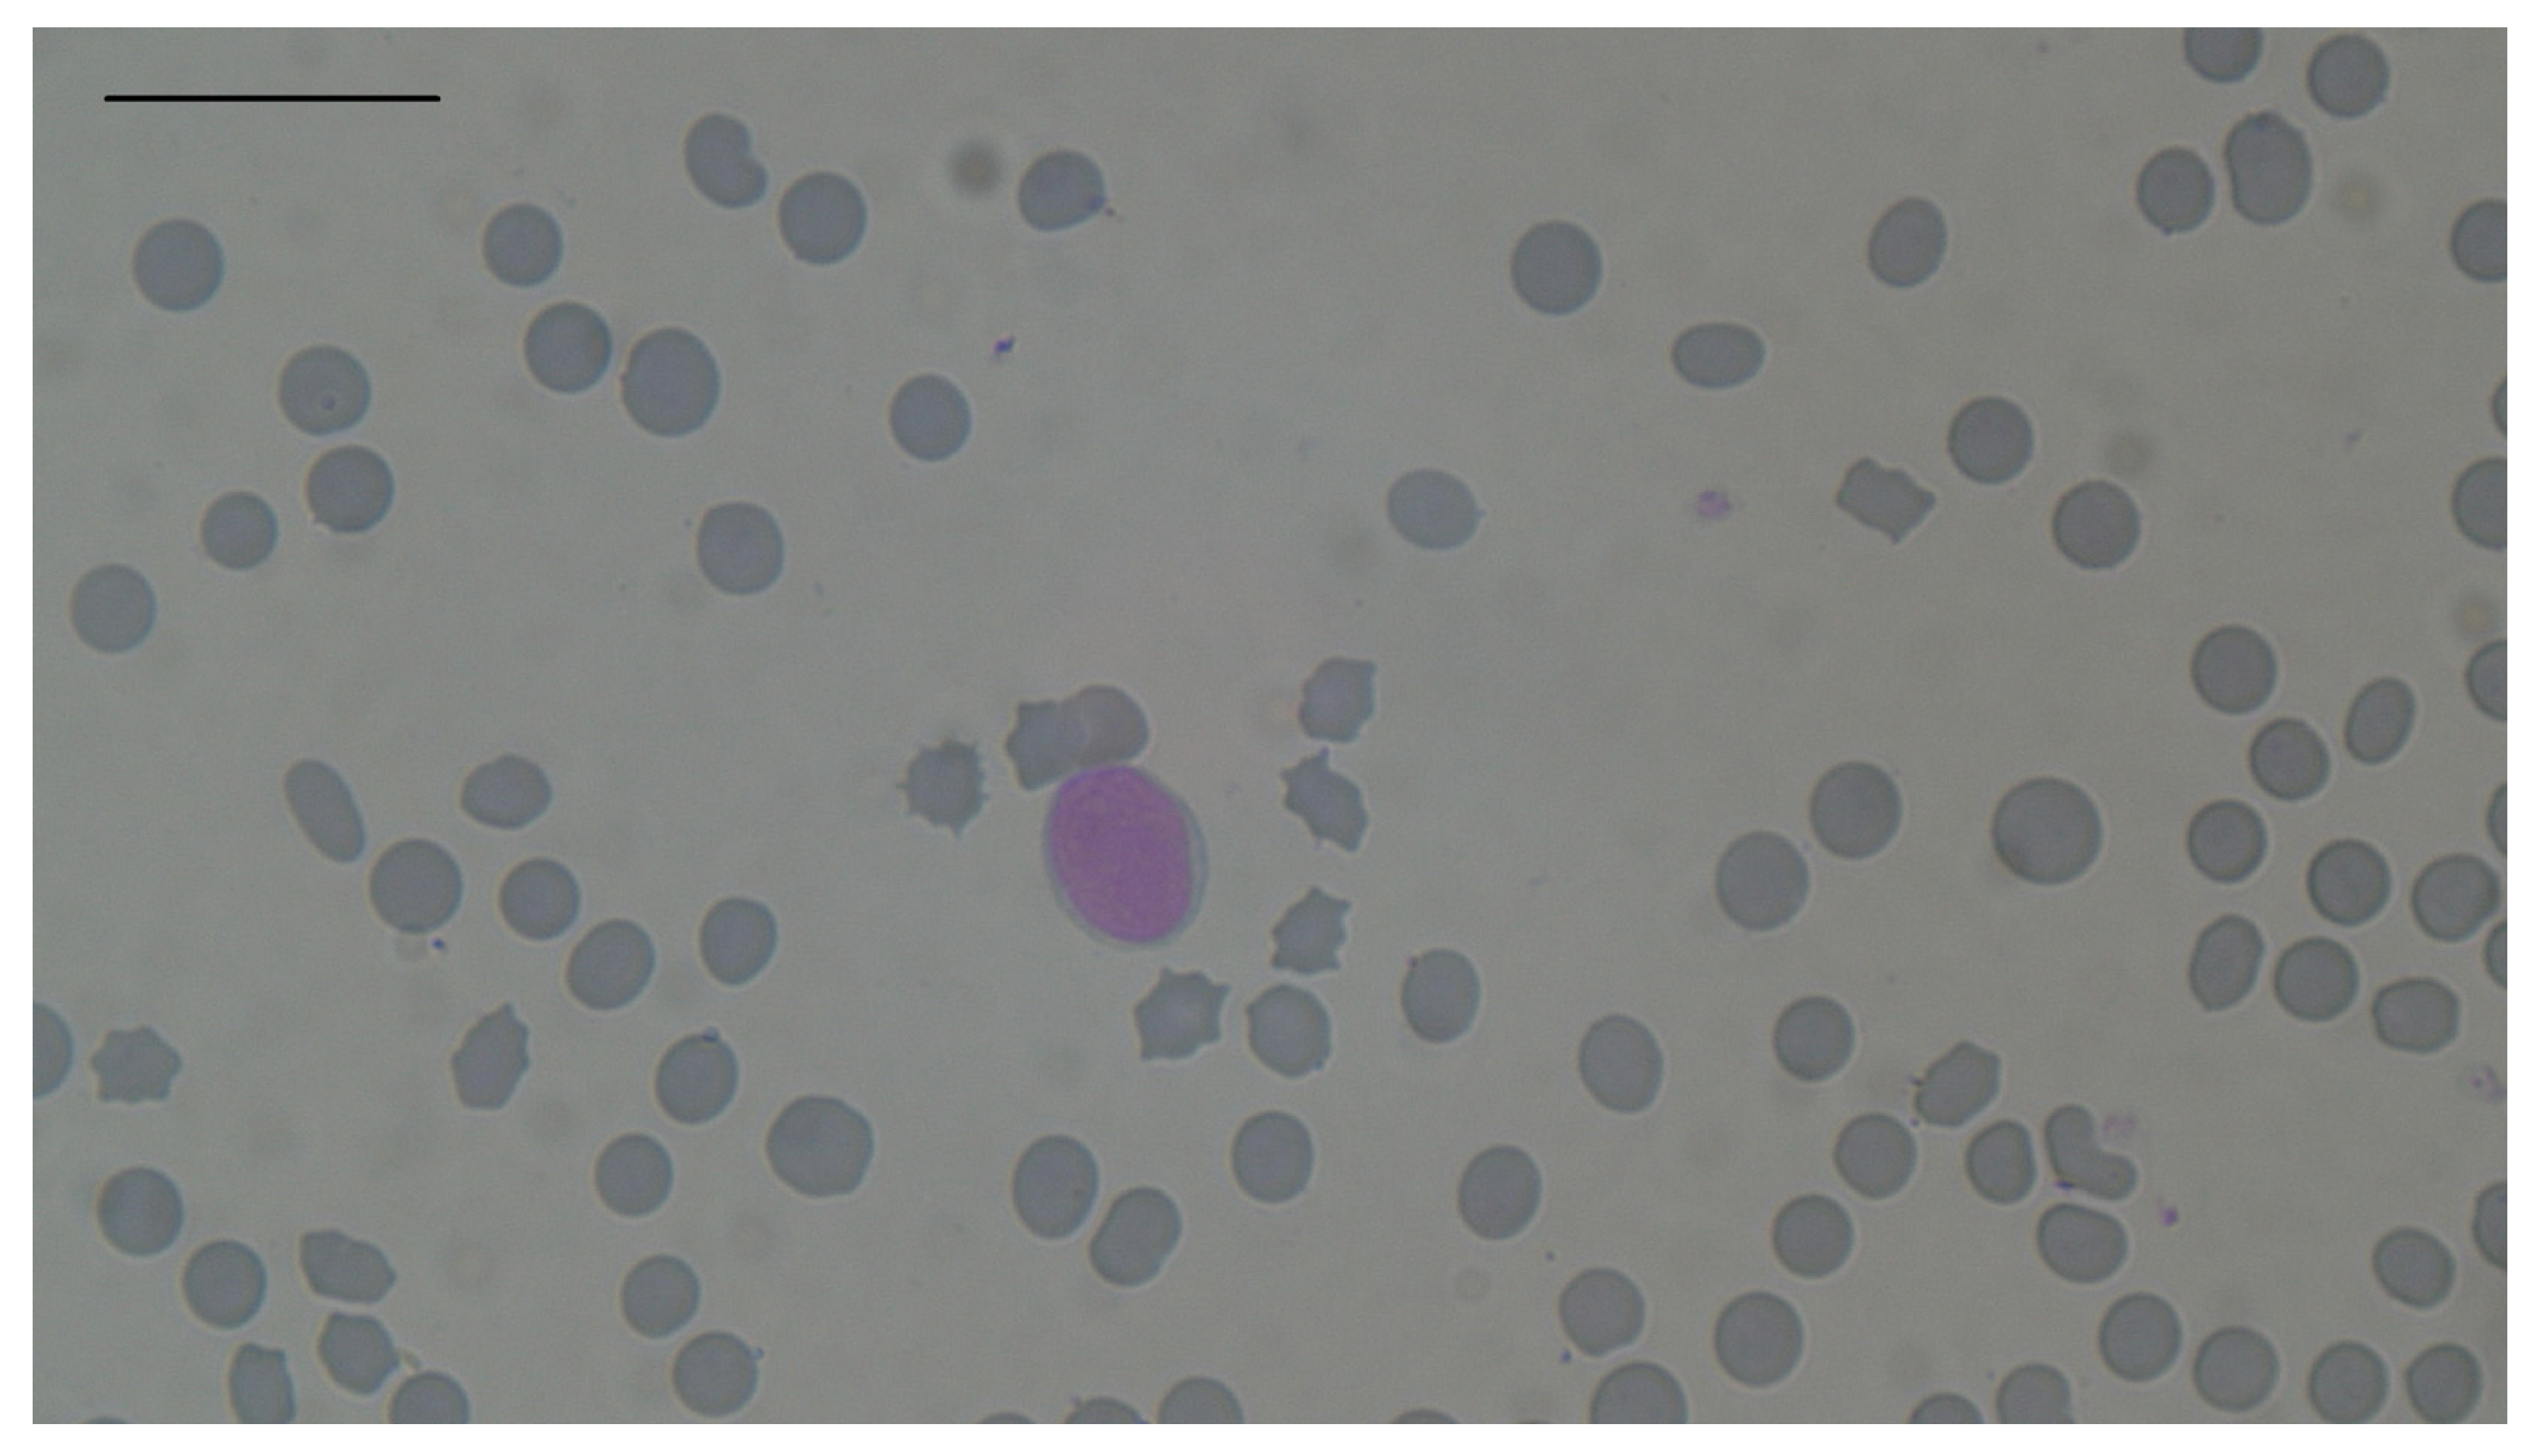

Changes in Erythrocytes in 88 Hyperthyroid Cats
Simple Summary
Abstract
1. Introduction
2. Materials and Methods
2.1. Study Design
2.2. Blood and Serum Analysis
2.3. Statistical Analysis
3. Results
3.1. Distribution of Variables in 88 Hyperthyroid Cats
3.2. Distribution of Age, T4 Concentration and Erythrocyte Parameters in Males and Females, and Differences Between Sex Groups
3.3. Prevalence of Erythrocytosis, Anaemia, Macro- and Microcytosis, Hypochromia, and Influence of Sex on These Changes
3.4. Influence of Age and T4 Concentration on RBC Count, Hb Concentration, Hct, MCV and RDW-CV in 88 Hyperthyroid Cats
3.5. Correlations Between Erythrocyte Parameters in 88 Hyperthyroid CATS
3.6. Correlations of RBC Count and MCV with Serum Concentrations of Sodium, Total Protein, Albumin, Urea and Creatinine in 88 Hyperthyroid Cats
3.7. Influence of Antithyroid Therapy on RBC Count and MCV
4. Discussion
4.1. Lack of Influence of Sex, Age, and T4 Concentration on Erythrocyte Parameters
4.2. Microcytosis
4.3. Macrocytosis
4.4. Anaemia
4.5. Erythrocytosis
4.6. Correlations Between Erythrocyte Parameters; Moderate Negative Correlation Between RBC Count and MCV
4.7. Limitations
5. Conclusions
Supplementary Materials
Author Contributions
Funding
Institutional Review Board Statement
Informed Consent Statement
Data Availability Statement
Conflicts of Interest
References
- Peterson, M. Hyperthyroidism in cats: What’s causing this epidemic of thyroid disease and can we prevent it? J. Feline. Med. Surg. 2012, 14, 804–818. [Google Scholar] [CrossRef] [PubMed]
- Bree, L.; Gallagher, B.A.; Shiel, R.E.; Mooney, C.T. Prevalence and risk factors for hyperthyroidism in Irish cats from the greater Dublin area. Ir. Vet. J. 2018, 71, 2. [Google Scholar] [CrossRef] [PubMed]
- Gójska-Zygner, O.; Lechowski, R.; Zygner, W. Prevalence of feline hyperthyroidism in mature cats in urban population in Warsaw. Bull. Vet. Inst. Pulawy 2014, 58, 267–271. [Google Scholar] [CrossRef]
- Peterson, M.E.; Kintzer, P.P.; Cavanagh, P.G.; Fox, P.R.; Ferguson, D.C.; Johnson, G.F.; Becker, D.V. Feline hyperthyroidism: Pretreatment clinical and laboratory evaluation of 131 cases. J. Am. Vet. Med. Assoc. 1983, 183, 103–110. [Google Scholar]
- Broussard, J.D.; Peterson, M.E.; Fox, P.R. Changes in clinical and laboratory findings in cats with hyperthyroidism from 1983 to 1993. J. Am. Vet. Med. Assoc. 1995, 206, 302–305. [Google Scholar] [CrossRef]
- Thoday, K.L.; Mooney, C.T. Historical, clinical and laboratory features of 126 hyperthyroid cats. Vet. Rec. 1992, 131, 257–264. [Google Scholar] [CrossRef]
- Gil-Morales, C.; Costa, M.; Tennant, K.; Hibbert, A. Incidence of microcytosis in hyperthyroid cats referred for radioiodine treatment. J. Feline Med. Surg. 2021, 23, 928–935. [Google Scholar] [CrossRef]
- Loftus, J.P.; DeRosa, S.; Struble, A.M.; Randolph, J.F.; Wakshlag, J.J. One-year study evaluating efficacy of an iodine-restricted diet for the treatment of moderate-to-severe hyperthyroidism in cats. Vet. Med. Res. Rep. 2019, 10, 9–16. [Google Scholar] [CrossRef]
- Granat, F.; Geffré, A.; Bourgès-Abella, N.; Mortier, J.; Théron, M.L.; Fauchon, E.; Braun, J.P.; Trumel, C. Feline reference intervals for the Sysmex XT-2000iV and the ProCyte DX haematology analysers in EDTA and CTAD blood specimens. J. Feline Med. Surg. 2014, 16, 473–482. [Google Scholar] [CrossRef]
- Wopereis, D.M.; Du Puy, R.S.; van Heemst, D.; Walsh, J.P.; Bremner, A.; Bakker, S.J.L.; Bauer, D.C.; Cappola, A.R.; Ceresini, G.; Degryse, J.; et al. The Relation Between Thyroid Function and Anemia: A Pooled Analysis of Individual Participant Data. J. Clin. Endocrinol. Metab. 2018, 103, 3658–3667. [Google Scholar] [CrossRef]
- Peterson, M.E. Animal models of disease: Feline hyperthyroidism: An animal model for toxic nodular goiter. J. Endocrinol. 2014, 223, T97–T114. [Google Scholar] [CrossRef] [PubMed]
- De Leo, S.; Lee, S.Y.; Braverman, L.E. Hyperthyroidism. Lancet 2016, 388, 906–918. [Google Scholar] [CrossRef] [PubMed]
- Peterson, M.E.; Graves, T.K.; Cavanagh, I. Serum Thyroid Hormone Concentrations Fluctuate in Cats with Hyperthyroidism. J. Vet. Intern. Med. 1987, 1, 142–146. [Google Scholar] [CrossRef]
- Abrams-Ogg, A. Nonregenerative Anemia. In Textbook of Veterinary Internal Medicine, 7th ed.; Ettinger, S.J., Feldman, E.C., Eds.; Elsevier: St. Louis, MO, USA, 2010; pp. 788–797. [Google Scholar]
- Paltrinieri, S.; Ibba, F.; Rossi, G. Haematological and biochemical reference intervals of four feline breeds. J. Feline Med. Surg. 2014, 16, 125–136. [Google Scholar] [CrossRef]
- How, J.; Davidson, R.J.; Bewsher, P.D. Red Cell Changes in Hyperthyroidism. Scand. J. Haematol. 1979, 23, 323–328. [Google Scholar] [CrossRef]
- Kawa, M.P.; Grymuła, K.; Paczkowska, E.; Baśkiewicz-Masiuk, M.; Dąbkowska, E.; Koziołek, M.; Tarnowski, M.; Kłos, P.; Dziedziejko, V.; Kucia, M.; et al. Clinical relevance of thyroid dysfunction in human haematopoiesis: Biochemical and molecular studies. Eur. J. Endocrinol. 2010, 162, 295–305. [Google Scholar] [CrossRef]
- Johnson-Wimbley, T.D.; Graham, D.Y. Diagnosis and management of iron deficiency anemia in the 21st century. Therap. Adv. Gastroenterol. 2011, 4, 177–184. [Google Scholar] [CrossRef] [PubMed]
- Lakatos, P.; Foldes, J.; Horvath, C.; Kiss, L.; Tatrai, A.; Takacs, I.; Tarjan, G.; Stern, P.H. Serum Interleukin-6 and Bone Metabolism in Patients with Thyroid Function Disorders. J. Clin. Endocrinol. Metab. 1997, 82, 78–81. [Google Scholar] [CrossRef]
- Salvi, M.; Girasole, G.; Pedrazzoni, M.; Passeri, M.; Giuliani, N.; Minelli, R.; Braverman, L.E.; Roti, E. Increased serum concentrations of interleukin-6 (IL-6) and soluble IL-6 receptor in patients with Graves’ disease. J. Clin. Endocrinol. Metab. 1996, 81, 2976–2979. [Google Scholar]
- Wrighting, D.M.; Andrews, N.C. Interleukin-6 induces hepcidin expression through STAT3. Blood 2006, 108, 3204–3209. [Google Scholar] [CrossRef]
- Rodriguez, R.; Jung, C.L.; Gabayan, V.; Deng, J.C.; Ganz, T.; Nemeth, E.; Bulut, Y. Hepcidin Induction by Pathogens and Pathogen-Derived Molecules Is Strongly Dependent on Interleukin-6. Infect. Immun. 2014, 82, 745–752. [Google Scholar] [CrossRef] [PubMed]
- Fischli, S.; von Wyl, V.; Trummler, M.; Konrad, D.; Wueest, S.; Ruefer, A.; Heering, K.; Streuli, R.; Steuer, C.; Bernasconi, L.; et al. Iron metabolism in patients with Graves’ hyperthyroidism. Clin. Endocrinol. 2017, 87, 609–616. [Google Scholar] [CrossRef] [PubMed]
- Krygier, A.; Szczepanek-Parulska, E.; Filipowicz, D.; Ruchała, M. Changes in serum hepcidin according to thyrometabolic status in patients with Graves’ disease. Endocr. Connect. 2020, 9, 234–242. [Google Scholar] [CrossRef]
- Javard, R.; Grimes, C.; Bau-Gaudreault, L.; Dunn, M. Acute-Phase Proteins and Iron Status in Cats with Chronic Kidney Disease. J. Vet. Intern. Med. 2017, 31, 457–464. [Google Scholar] [CrossRef] [PubMed]
- Philipsen, J.P.; Madsen, K.V. Hypo- and hypernatremia results in inaccurate erythrocyte mean corpuscular volume measurement in vitro, when using Sysmex XE 2100. Scand. J. Clin. Lab. Invest. 2015, 75, 588–594. [Google Scholar] [CrossRef]
- Reed, J.P.; Hendley, E.D. Blood cell changes in spontaneously hypertensive rats are not all associated with the hypertensive phenotype. J. Hypertens. 1994, 12, 391–399. [Google Scholar] [CrossRef]
- Cook, A.K.; Suchodolski, J.S.; Steiner, J.M.; Robertson, J.E. The prevalence of hypocobalaminaemia in cats with spontaneous hyperthyroidism. J. Small. Anim. Pract. 2011, 52, 101–106. [Google Scholar] [CrossRef]
- Geesaman, B.M.; Whitehouse, W.H.; Viviano, K.R. Serum Cobalamin and Methylmalonic Acid Concentrations in Hyperthyroid Cats Before and After Radioiodine Treatment. J. Vet. Intern. Med. 2016, 30, 560–565. [Google Scholar] [CrossRef]
- Snow, C.F. Laboratory Diagnosis of Vitamin B12 and Folate Deficiency: A Guide for the Primary Care Physician. Arch. Intern. Med. 1999, 159, 1289–1298. [Google Scholar] [CrossRef]
- Simpson, K.W.; Fyfe, J.; Cornetta, A.; Sachs, A.; Strauss-Ayali, D.; Lamb, S.V.; Reimers, T.J. Subnormal Concentrations of Serum Cobalamin (Vitamin B12) in Cats with Gastrointestinal Disease. J. Vet. Intern. Med. 2001, 15, 26–32. [Google Scholar] [CrossRef]
- Gianoukakis, A.G.; Leigh, M.J.; Richards, P.; Christenson, P.D.; Hakimian, A.; Fu, P.; Niihara, Y.; Smith, T.J. Characterization of the anaemia associated with Graves’ disease. Clin. Endocrinol. 2009, 70, 781–787. [Google Scholar] [CrossRef] [PubMed]
- Das, K.C.; Mukherjee, M.; Sarkar, T.K.; Dash, R.J.; Rastogi, G.K. Erythropoiesis and Erythropoietin in Hypo- and Hyperthyroidism. J. Clin. Endocrinol. Metab. 1975, 40, 211–220. [Google Scholar] [CrossRef] [PubMed]
- Sehgal, S.; Tamatea, J.A.U.; Conaglen, J.V.; Elston, M.S. Anaemia and thyrotoxicosis: The need to look for an alternative cause. Clin. Endocrinol. 2018, 88, 957–962. [Google Scholar] [CrossRef] [PubMed]
- Noszczyk-Nowak, A.; Pasławska, U.; Skrzypczak, P.; Nicpoń, J.; Gajek, J.; Zysko, D. Symptoms, biochemical and hematological blood parameters in pigs in the course of experimental hyperthyroidism. Med. Weter. 2007, 63, 219–223. [Google Scholar]
- Ahmed, S.S.; Mohammed, A.A. Effects of thyroid dysfunction on hematological parameters: Case controlled study. Ann. Med. Surg. 2020, 57, 52–55. [Google Scholar] [CrossRef]
- Liu, X.; Liu, J.; Fan, L.; Shi, B. Erythrocytosis associated with hyperthyroidism: A rare case report and clinical study of possible mechanism. Endocr. Res. 2015, 40, 177–180. [Google Scholar] [CrossRef]
- Otto, T.; Fandrey, J. Thyroid Hormone Induces Hypoxia-Inducible Factor 1α Gene Expression through Thyroid Hormone Receptor β/Retinoid X Receptor α-Dependent Activation of Hepatic Leukemia Factor. Endocrinology 2008, 149, 2241–2250. [Google Scholar] [CrossRef]
- Fandrey, J.; Pagel, H.; Frede, S.; Wolff, M.; Jelkmann, W. Thyroid hormones enhance hypoxia-induced erythropoietin production in vitro. Exp. Hematol. 1994, 22, 272–277. [Google Scholar]
- Desouza, L.A.; Sathanoori, M.; Kapoor, R.; Rajadhyaksha, N.; Gonzalez, L.E.; Kottmann, A.H.; Tole, S.; Vaidya, V.A. Thyroid Hormone Regulates the Expression of the Sonic Hedgehog Signaling Pathway in the Embryonic and Adult Mammalian Brain. Endocrinology 2011, 152, 1989–2000. [Google Scholar] [CrossRef]
- Perry, J.M.; Harandi, O.F.; Porayette, P.; Hegde, S.; Kannan, A.K.; Paulson, R.F. Maintenance of the BMP4-dependent stress erythropoiesis pathway in the murine spleen requires hedgehog signaling. Blood 2009, 113, 911–918. [Google Scholar] [CrossRef]
- Paulson, R.F.; Hariharan, S.; Little, J.A. Stress erythropoiesis: Definitions and models for its study. Exp. Hematol. 2020, 89, 43–54. [Google Scholar] [CrossRef] [PubMed]
- Sivertsson, E.; Friederich-Persson, M.; Persson, P.; Nangaku, M.; Hansell, P.; Palm, F. Thyroid hormone increases oxygen metabolism causing intrarenal tissue hypoxia; a pathway to kidney disease. PLoS ONE 2022, 17, e0264524. [Google Scholar] [CrossRef]
- Saleban, M.; Harris, E.L.; Poulter, J.A. D-Type Cyclins in Development and Disease. Genes 2023, 14, 1445. [Google Scholar] [CrossRef]
- Sankaran, V.G.; Ludwig, L.S.; Sicinska, E.; Xu, J.; Bauer, D.E.; Eng, J.C.; Patterson, H.C.; Metcalf, R.A.; Natkunam, Y.; Orkin, S.H.; et al. Cyclin D3 coordinates the cell cycle during differentiation to regulate erythrocyte size and number. Genes Dev. 2012, 26, 2075–2087. [Google Scholar] [CrossRef]
- Sterle, H.A.; Valli, E.; Cayrol, F.; Paulazo, M.A.; Martinel Lamas, D.J.; Diaz Flaqué, M.C.; Klecha, A.J.; Colombo, L.; Medina, V.A.; Cremaschi, G.A.; et al. Thyroid status modulates T lymphoma growth via cell cycle regulatory proteins and angiogenesis. J. Endocrinol. 2014, 222, 243–255. [Google Scholar] [CrossRef]
- Meng, S.; Badrinarain, J.; Sibley, E.; Fang, R.; Hodin, R. Thyroid Hormone and the D-Type Cyclins Interact in Regulating Enterocyte Gene Transcription. J. Gastrointest. Surg. 2001, 5, 49–55. [Google Scholar] [CrossRef] [PubMed]
- Paternot, S.; Dumont, J.E.; Roger, P.P. Differential Utilization of Cyclin D1 and Cyclin D3 in the Distinct Mitogenic Stimulations by Growth Factors and TSH of Human Thyrocytes in Primary Culture. Mol. Endocrinol. 2006, 20, 3279–3292. [Google Scholar] [CrossRef] [PubMed][Green Version]
- Balzan, S.; Nicolini, G.; Forini, F.; Boni, G.; Del Carratore, R.; Nicolini, A.; Carpi, A.; Iervasi, G. Presence of a functional TSH receptor on human erythrocytes. Biomed. Pharmacother. 2007, 61, 463–467. [Google Scholar] [CrossRef]
- Vieira, I.H.; Rodrigues, D.; Paiva, I. The Mysterious Universe of the TSH Receptor. Front. Endocrinol. 2022, 13, 944715. [Google Scholar] [CrossRef]
- Devereaux, D.; Tewelde, S.Z. Hyperthyroidism and Thyrotoxicosis. Emerg. Med. Clin. North. Am. 2014, 32, 277–292. [Google Scholar] [CrossRef]
- Peterson, M.E.; Guterl, J.N.; Nichols, R.; Rishniw, M. Evaluation of Serum Thyroid-Stimulating Hormone Concentration as a Diagnostic Test for Hyperthyroidism in Cats. J. Vet. Intern. Med. 2015, 29, 1327–1334. [Google Scholar] [CrossRef] [PubMed]
- Montagnana, M.; Lippi, G.; Franchini, M.; Guidi, G.C. The erythrocyte mean corpuscular volume is associated with serum levels of thyroid stimulating hormone in women. Am. J. Hematol. 2008, 83, 258. [Google Scholar] [CrossRef] [PubMed]
- Leberbauer, C.; Boulmé, F.; Unfried, G.; Huber, J.; Beug, H.; Müllner, E.W. Different steroids co-regulate long-term expansion versus terminal differentiation in primary human erythroid progenitors. Blood 2005, 105, 85–94. [Google Scholar] [CrossRef] [PubMed]
- Bianco, A.C.; Kim, B.W. Deiodinases: Implications of the local control of thyroid hormone action. J. Clin. Investig. 2006, 116, 2571–2579. [Google Scholar] [CrossRef] [PubMed]
- van Beaumont, W.; Underkofler, S.; van Beaumont, S. Erythrocyte volume, plasma volume, and acid-base changes in exercise and heat dehydration. J. Appl. Physiol. Respir. Environ. Exerc. Physiol. 1981, 50, 1255–1262. [Google Scholar] [CrossRef]
- Amakasu, K.; Suzuki, K.; Katayama, K.; Suzuki, H. Age-Related Pathophysiological Changes in Rats with Unilateral Renal Agenesis. J. Vet. Med. Sci. 2011, 73, 787–795. [Google Scholar] [CrossRef][Green Version]
- Tasker, S. Hemotropic Mycoplasma. Vet. Clin. North. Am. Small Anim. Pract. 2022, 52, 1319–1340. [Google Scholar] [CrossRef]
- Álvarez-Fernández, A.; Breitschwerdt, E.B.; Solano-Gallego, L. Bartonella infections in cats and dogs including zoonotic aspects. Parasit. Vectors 2018, 11, 624. [Google Scholar] [CrossRef]
- Keohane, C.; McMullin, M.F.; Harrison, C. The diagnosis and management of erythrocytosis. BMJ 2013, 347, f6667. [Google Scholar]
- McMullin, M.F. The classification and diagnosis of erythrocytosis. Int. J. Lab. Hematol. 2008, 30, 447–459. [Google Scholar]
- Randolph, J.F.; Peterson, M.E.; Stokol, T. Erythrocytosis and Polycythemia. In Schalm’s Veterinary Hematology, 6th ed.; Weiss, D.J., Wardrop, K.J., Eds.; Blackwell Publishing: Ames, IA, USA, 2010; pp. 162–166. [Google Scholar]
- Christopher, M.M. Relation of endogenous Heinz bodies to disease and anemia in cats: 120 cases (1978–1987). J. Am. Vet. Med. Assoc. 1989, 194, 1089–1095. [Google Scholar] [PubMed]

| Variable | Males | Females | U | p | |||
|---|---|---|---|---|---|---|---|
| Med. | 25–75th% | Med. | 25–75th% | ||||
| T4 nmol/L | 81.5 | 69–109 | 94.5 | 73–143 | 790 | 0.143 | |
| RDW-CV % | 23.2 | 20.9–24.3 | 23.25 | 20.4–24.1 | 924.5 | 0.732 | |
| RBC Change | χ2 | p | Number of Hyperthyroid Cats |
|---|---|---|---|
| Erythrocytosis | 0.05 | 0.824 | 36 males with normal RBC count, 5 males with erythrocytosis |
| 36 females with normal RBC count, 7 females with erythrocytosis | |||
| Anaemia | 0.21 | 0.646 | 36 males with normal RBC count, 1 male with anaemia |
| 36 females with normal RBC count, 3 females with anaemia | |||
| Macrocytosis | 0.40 | 0.527 | 40 males with normal MCV, 0 males with increased MCV |
| 43 females with normal MCV, 2 females with increased MCV | |||
| Microcytosis | 0.00 | 0.967 | 40 males with normal MCV, 2 males with decreased MCV |
| 43 females with normal MCV, 1 female with decreased MCV |
| Correlations | Age of Cats | T4 Concentration | ||
|---|---|---|---|---|
| r | p | R | p | |
| RBC count | 0.0056 | 0.959 | −0.1142 | 0.289 |
| Hb concentration | 0.0143 | 0.895 | −0.141 | 0.190 |
| Hct | 0.0372 | 0.731 | 0.019 | 0.858 |
| MCV | 0.0698 | 0.518 | 0.136 | 0.207 |
| RDW-CV | −0.059 * | 0.584 | −0.087 | 0.420 |
| Correlation | Sodium | Total Protein | Albumin | Urea | Creatinine |
|---|---|---|---|---|---|
| RBC | r: 0.198, p: 0.064 | R: 0.159, p: 0.139 | R: 0.032, p: 0.767 | r: −0.249, p: 0.019 | R: 0.019, p: 0.857 |
| MCV | r: −0.074, p: 0.491 | R: −0.085, p: 0.432 | R: 0.062, p: 0.562 | r: 0.257, p: 0.016 | R: 0.023, p: 0.831 |
Disclaimer/Publisher’s Note: The statements, opinions and data contained in all publications are solely those of the individual author(s) and contributor(s) and not of MDPI and/or the editor(s). MDPI and/or the editor(s) disclaim responsibility for any injury to people or property resulting from any ideas, methods, instructions or products referred to in the content. |
© 2024 by the authors. Licensee MDPI, Basel, Switzerland. This article is an open access article distributed under the terms and conditions of the Creative Commons Attribution (CC BY) license (https://creativecommons.org/licenses/by/4.0/).
Share and Cite
Gójska-Zygner, O.; Kotomski, G.; Gajger, J.; Norbury, L.J.; Zygner, W. Changes in Erythrocytes in 88 Hyperthyroid Cats. Animals 2024, 14, 3136. https://doi.org/10.3390/ani14213136
Gójska-Zygner O, Kotomski G, Gajger J, Norbury LJ, Zygner W. Changes in Erythrocytes in 88 Hyperthyroid Cats. Animals. 2024; 14(21):3136. https://doi.org/10.3390/ani14213136
Chicago/Turabian StyleGójska-Zygner, Olga, Grzegorz Kotomski, Joanna Gajger, Luke J. Norbury, and Wojciech Zygner. 2024. "Changes in Erythrocytes in 88 Hyperthyroid Cats" Animals 14, no. 21: 3136. https://doi.org/10.3390/ani14213136
APA StyleGójska-Zygner, O., Kotomski, G., Gajger, J., Norbury, L. J., & Zygner, W. (2024). Changes in Erythrocytes in 88 Hyperthyroid Cats. Animals, 14(21), 3136. https://doi.org/10.3390/ani14213136

